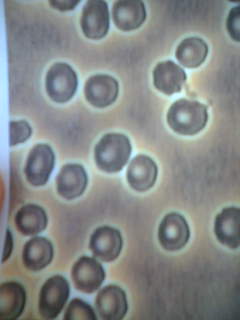

全247件 (247件中 1-50件目)
すごく久々の更新だ…。2年ぶり? パチンコは続けているが、厳しい状況。 今年はなんと今のところマイナス収支だし。 --- wrote:
2010年04月21日
ここ数年のパチンコ人生(大げさか…)当初ほどの情熱はなくなっている気がする。と仕事中に書いてアップした私ですが。行ってきました新台入れ替えにいそいそとたまたま空いたベルバラへ座れた。あんまり回らないし台はピカピカ光ってドライアイ気味の私にはつらいわ。¥19500でやっとあたり4連荘。ストレートで飲まれて…撃沈。前言撤回→ やっぱりパチンコに情熱あります。私。--- wrote:
2009年06月11日
去年の11月ぶりの更新。一応書いておこうっと。昨年のパチンコ収支は…¥295000のプラス今年は…といってももう6月。パチンコは渋い状況でやっとプラス¥49700になったとこ。最近はバカボンをよく打ってるけどこの台楽しいね。最近は大阪も換金3円がメインです。わたしも今年は3円ばっかり。今日はまっすぐ帰ってきてサッカー観戦。ビールを飲みながら!結果は引き分け。中澤の悔しそうな顔が印象的だった。
2009年06月10日
またまた名古屋へ旅打ち金曜日仕事帰りに近鉄特急で名古屋へGO!2週間前と同じホテルでおなじ居酒屋…。シモンズベッドでぐっすり眠って8:00起床。コンビニで買っておいた朝ごはんを食べてサンシャイン京樂へ。今日は月一イベントで特にアバンギャルドがオススメ台。9時5分過ぎに着いたのだけど、すでに満席。仕方なく地下へ降りてGAROを打つ。¥2000であたった。初めての当りで出目は3例の魔界モード(?だっけ)にはいることは分かったのでどきどき。消化中は右うち?左うち?混乱のうちに3回で終了。次は2箱なくなりかけで単発。25回転で単発。また3箱にもどり今度は2箱半つかったところで3で大当り。今度は冷静に魔界モードに突入。これが7連荘して余裕の展開。ところが、これが全部ストレートで飲まれ…撃沈。と彼のほうはと…夏祭りで大爆発。大量出玉をもっていたので隣に座り、玉をもらう。いったりきたりでタイムリミットの7時過ぎには結局1杯。彼に返却して終わり。彼は10万勝ち私は投資¥2000 換金¥0の¥2000負け。20:00の特急で大阪へ。つかれたよ~。しばらく名古屋はやめとこう。
2008年11月22日
仕事帰りいつものG店へ。北斗¥500 回らず移動¥2000やっぱり回らず移動。いつも打つ台。すでに38回あたっている。さっきまでは人がいたのだが、空いたので座る。カウントは16回転。まさかねーはいってないよねー投資¥1000で当り。五者星リーチ(この字?)の海まで行ってプレミアム。8連荘(6*16R 2*5R)あまりまわらなかったし、1箱入れてやめ。投資¥3500換金¥26500 ¥23000のプラス。
2008年11月20日
G店です。さかのぼって書いているので簡単に…仕事帰りにGO!北斗投資¥38500!!換金¥¥23900-¥14600はまってはまってつかれた。大分取り戻せて助かった。
2008年11月19日
さかのぼって書いているので簡単に…いつものG店何台か移動して投資¥12000で大当り。その後は当りまくって…(いままで最高15連荘)換金¥63600 ¥51600のプラス!
2008年11月17日
11時まで爆睡してパチンコへ3円換金のG店新台のガロ?を打つ。変わったスペックらしい。¥6000つかってやめ。おもしろくないし北斗へこの店は小当たりもすべてカウントする。で2回あたって36回転の台へオカマ掘りを期待して打つ^_^;¥2000で突通をひく…。さらに小当たり。¥4000でやめ別の北斗へ。結構回る。¥27000でやっとあたり。6連(すべて16R)つぎははやくて280回転で7連(5*16R 2*5R)次が数回転で3連(2*16R・1*5R)で約12箱?投資¥37000換金¥56500 ¥19500のプラス。明日はゆっくり。髪きりにいく予定。
2008年11月15日
仕事帰り。3円換金のG店へ北斗を打つ。¥15000で当り。引き戻しもあり10連(8*16R 2*5R)時間もなかったので一箱いれて7箱ながす。投資¥15000換金¥35000 ¥20000のプラス。うれし。最近好調
2008年11月13日
仕事帰りいつものG店北斗を打つ。¥10000打ったところで彼から連絡。お食事のおさそい。おごりだってもう¥10000つかってたから、ちっと悩みましたが、おなかもへってたし、ごはんへGO!「肉食べたい!」と主張して焼肉へ。いつもいく紋次郎へ。この店いいですよ。肉質抜群。値段はお手ごろ。大好きな生レバとランプをたらふく。パチンコは中途ハンバでしたが、満腹満腹。
2008年11月12日
仕事かえり。今日は久しぶりにExcelのマクロで頭をつかった~。疲れた。疲れてたけど、パチンコへGO!3円換金のG店へ。大海¥9500→確変ワンセット→全部のまれた。北斗¥500(2回転であたり!!!)→5連荘(5R*3 16R*2)のまれかけで→2連荘(16R*2) 時間がないので即やめ投資¥10000換金¥10000プラスおかし。疲れたよ~。明日はパチンコは休もうっと。体力もたん…
2008年11月11日
最近3円換金になったN店仕事帰りにGO!北斗¥500→やめバーチャファイター¥2000→やめまわらないね~アバンギャルド¥9000→2・1・2・4 6箱ながしました。投資¥11500換金¥28100¥16600のプラス!!
2008年11月10日
金曜日の仕事帰りに近鉄の特急へ名古屋へ先月に引き続き今月も名古屋へ打ちにいきました。8時過ぎについてホテルへ。ホテルの近くにおいしい居酒屋を前回見つけたので今回もその店へ(実はこっちのほうが目的だったりします。)いっくうというお店ですが、石焼シーフードグラタンが最高!!!さて翌日。名古屋は9時開店ですが、サンシャイン京樂へついたのは10時半頃。前回冬ソナでやられたので、今回こそはリベンジ。イベントの必殺…¥16000使ったところでやめ。地下へ移動。大夏祭り¥2000→あたらずやめ大海¥14000→単発→のまれてやめ。ジョーズ¥7000→あたらずやめアバンギャルド¥3000→単発。のまれて追加¥1000→3・10・1・5・2・1とあたりまくり19箱ながしました。投資¥43000換金¥90000 ¥47000のぷらす!どーなることかとおもったけど…助かった。あわてて20:00の特急でかえりました。家についたのが23:00前。疲れた~。
2008年11月08日
ブログを書くと調子がいいのか?昨日仕事帰りにGO!G店 3円換金¥5500で単発時短中に単発112回で単発一箱少しで単発299回転でやっと確変 3連荘一箱いれてヤメ三箱流して¥13300の換金¥7800のプラス本日昨日と同店。本日も大海¥3000で確変2回178回転で2回時短中に突確確変で3回6箱になってそこから約3箱。530回転で7連荘!!時間もないので時短即やめ10箱流して¥44500の換金。¥41500のプラス。明日の仕事帰りは持病の通院為パチンコはお休み心置きなくやすめます。
2008年11月05日
6月以来の更新なので、5ヶ月ぶり。最後のブログを読んでみるとパチンコは絶好調ですな。あの日以降の収支は書くのもイヤになる展開です。6月14,900-6,00048,900-14,0007,000-4,700-28,500-10,000-2,700-8,00070047,400-19,000-21,200-500-11,400-6,70029,0006月合計¥152007月-14,50026,00012,400-28,500-34,000-35,00010,000-1,000-30,0003,100-35,00033,500-40,0002,700-41,000-13,500-7,500-47,000-27,0006,200-38,0007月合計¥-298,1008月26,50025,400-2,100-1,000-35,0003008,50022,200-37,00012,400-34,0002,300-23,000-9,800-15,0009,2008月合計¥-50,1009月31,00014,200-5,000-30,00068,500-48,00012,50034,90021,400-39,00019,9004,900-43,00026,50045,100-47,00012,10013,1009月合計¥92,10010月24,000-33,00061,0001,500-23,00029,10030,700-35,000-200-23,0005,10013,80020,400-2,000900-10,600-29,50040,90010月合計¥71,10011月-12,500-1,30015,100今年の累計¥289,9007月はほんとにひどく負けました。大海が出始めで打ちまくりましたが当らない…当らない…先月は名古屋へ行きました。サンシャイン京樂へ行って冬ソナを打ちましたが回らず当らず他店へ移動。北斗のイベントをやっている店で2日で6万の勝ち!でも北斗は名古屋に行く前の数日間で、大阪の某店で累計10万は入れましたが一度も当りを引けない状態。当りあるのこの台と不信感すら持っていたので名古屋でのあたりはほんとにうれしかったです。でも大阪では相変わらず北斗では勝てません。今年の目標は…残すとこ2ヶ月となりましたが、¥50万としたいと思います。
2008年11月03日
5月の続きの収支です。前半のボロ負けから一転勝ち街道まっしぐら9,80035,30021,5006003,700-15,50020,5006,20015,900ほとんどが3円換金の沖海です。昨日はひさびさに水戸黄門のハネデジです。今月収支¥74,800のプラス今年の累計¥458,400前半ほんとに悲惨だったので助かりました。6月も頑張るぞ
2008年06月01日
続きの収支です。4月10,900-12,0004月合計 ¥169,000のプラス!!5月が悲惨です。4月ラストの負けからそのまま負け街道まっしぐら。最高でマイナス¥120000を超えたところでさすがに連敗ストップ。今週は大分持ち直しました-25,900-33,500-27,00022,600-11,300-25,000-15,000-2,200-6,00068,80022,9008,4005月-23,200でもまだ負けています…とりあえずプラスに転じねば…今年収支は¥360,400のプラスそれにしても冬ソナ2は勝てません。小当たりがやたら当ってカウントされるのがむかつくわ~あのミニョンモードは不要だと思います。勝ち分はもっぱら沖海です。あまりに負けるので3円換金も店へ変更しました。今年に入ってずっとお世話になっていた2.38円換金の店にはしばらく行かないつもり。今日はゆっくりしたので明日は朝から打ちにいこうっと。
2008年05月17日
久々更新。最近はルパンにはまって打っています前回からの収支です。3月続き23,2007,400-22,000-29,400-35,000-17,70047,8003月合計 ¥126,100のプラスMAXは18万まで行ってましたが、そんなに甘くありません。でも大勝です。ありがたい。4月収支は-21,000-9,40046,00061,500-44,100-12,00012,000-70019,500-19,000-1,300-2,20034,80010041,00024,90040,0004月の累計¥170,100調子いいです。時に今週は珍しく5連勝仕事→パチンコの繰り返しでクタクタでした。今日は爆睡今月はマイナススタートでしたが、仕事で東京に行く機会があり、月曜日が仕事だったので土曜から東京へ行き、土曜・日曜と東京で打ちました。二日とも女性専用台を打ったのですが、3円換金で大阪より回る回る!二日で10万オーバー勝ちでした。あと先週の週末に名古屋へ行きました。下調べが足りずにロクな店でうてず、結局マイナス¥700でした。これでも助かったという感じです。東京ではちょっと太っ腹にフォアラバーガーというのを食べました。ステーキとフォアグラがはさんであってお値段なんと¥2600!!!でもとってもおいしかったです。でも東京価格ですな。食べ物は大阪のほうが安くていい!でもパチンコは東京のほうが断然いい!と思いました。
2008年04月26日
最近忙しくて全く更新できてません。前回からのパチンコ収支です。2月続き-9,400-18,000-46,50041,80019,600-15,000-1,000-10,00037,1002月合計 ¥56,200のプラス3月15,300-19,00029,100-17,000-8,00046,30011,800-3,00012,80016,40015,300-19,70010,70012,70016,10032,0003月合計 ¥151,800のプラス今年の収支 ¥240,300のプラス何が忙しいかというと…仕事+パチンコ が忙しい"^_^"最近打っているのは羽パチの水戸黄門。手堅く勝ててます。
2008年03月22日
久しぶりの更新…1月の続き16,400-21,000-42,0001月の収支は¥32,300のプラス。2月の収支21,50025,20051,900-26,60038,100-41,000-50,000-12,200-16,50016,200-2,60027,60026,000今のところの収支は…¥57,600MAXで11万まで行っていたのですが、なかなかうまくいきません。でも大分取り戻しました。最近は新エバを打っています。今年は低換金率のお店で地道に頑張っています。本業のほうは(PCヘルプデスク)今の職場は今年で3年目にに突入。いい環境の職場なので(苦手な人が若干1名いますが)上手に頑張っていこうと思います。去年申し込むだけで受けなかった情報セキュリティの試験合格目指して勉強するつもり。試験は10月だけど今からちょっとずつやろうと思ってます。パチンコも去年は収支が悪かったから今年はもっと増額めざしたいと思います。と今年の目標ばかりになってしまいましたが、もう2月も中旬(下旬?)だもんね。はやいな~。毎日大事にがんばろ
2008年02月18日
今年に入っての収支です。-45,00036,0005,0006,00050,500-11,50033,50023,000-32,000-9,0002,500-20,00024,000-11,500-19,00016,50029,900相変わらずよく行ってます^_^;今年の初打ちは家の近くの等価の店でストレートに大負け。気を引き締めてその後は等価・高価交換には行かないようにしています。打ってる台はほとんどコウダクミ。今のところ累計は¥78900。この調子でガンバロー
2008年01月27日
久々更新。11月の続き21,000-6,00012月の収支今月はよく行きました^_^; 結果は散々…-44,500-36,500-32,00052,50028,500-40,00039,5006,5007,500-500-29,5001,00033,000-4,500-40,0003,500-19,50015,00040,500-1,000-1,500-39,500-35,00012月合計-96,500今年トータル¥247,900のプラス。勝った日:92日負けた日:96日プラスではありますが-、厳しい一年でした。一年の半分はパチンコに行ったのね。すごいわ私。ほんとにパチンコ好き。仕事帰りがほとんどなので一回平均4時間くらいとしても720時間くらいは稼働してる。時給にすると¥300くらいか年の最初は目標120万などと書いてたが、はー遠く及ばず。ここ数年はずっと100万オーバーだったのだが。なぜ今年はこんなに駄目だったんだろう?来年に向けて原因を究明して反省しなくては来年も同じような結果になってしまうよね。
2007年12月30日
昨日お金をたくさん使ったし、稼ぐ気マンマンで仕事帰りにパチンコへ。N店のカリブを打つ¥1000 21回転S店へ移動¥2500 カリブ単発飲まれて122回転綱取¥6500コウダクミ¥6000カリブ¥4000アクエリオン¥20000まったく当らずトータル¥40000の負け泣くわ~
2007年11月27日
前回からの収支です。10,00042,500-14,500-45,00020,00029,50026,000-28,50023,00010月トータルプラス¥118,000(^^♪11月は…-30,00019,500-30,000-23,000-23,0005,50013,00051,50029,50033,000-44,00035,000変動が激しい。一時はマイナス8万以上負けてたのだが、大分取り戻した。今年の収支は¥369400目標金額は年の初めに120万と書いていましが、今は修正して50万としときます。今年の残りもわずかになりましが、達成できるよう頑張らなくては…最近はこうだくみをよく打ってます。ところで!!今日はひさびさに大きな買い物しました。バレンシアガの赤い長財布とドルガバのトートを買いました。ドルガバのトートは前に梅田の阪急で見て一目ぼれだったのだが、この2週間考えに考えた挙句に買いました。購入先は心斎橋の路面店。すっごい敷居が高くて(私には)久々緊張しました^_^;豹柄で黒のトリミングでカワイイのです。(値段もこのブランドにしてはカワイイ方。私には高いが…)大事に使おうと思います。稼がなくては
2007年11月26日
前回以降の収支です。ほんといったりきたりで…^_^;-2,00022,50010,000-25,0009,500昨日はペアパチ。T店で倖田來未を打った。彼が¥2000で確変ワンセット。あっさり飲まれて追加投資¥3000回りもいまいちになってきたのでT店は撤退。お昼ごはんを食べにいった。道頓堀の大阪ステーキというお店を発見。ロースステーキ¥900!お値段以上のおいしさでした。また絶対行く(^^♪食後は最近は足が遠のいていたN店へ。サクラ大戦がガラガラだったので打ちました。最近には珍しく¥1000で私が確変ゲット。4連荘。その後は飲まれることなくいったりきたりMAXでも5箱どまりで渋い展開。やっと9時以降に当りだし、10時に二人で7箱流して終了。二人でトータル¥12000投資 換金¥30500勝ててうれしいです。(前日¥25000も負けてたしね)今日は昼まで寝て家でごろごろ。来週と再来週は日帰り東京出張があるのだ。ExcelとPowerPointの講習会を東京本社でやるのでお手伝いに。マニュアル作成とサブインストラクタの役目が私。マニュアルは完成済み。頑張るぞ~!!!
2007年10月14日
一ヶ月以上の久々更新です。とりあえずパチンコ収支9月分3,00022,000-20,00020,000-15,000-25,400-40,000-1,400-19,000-19,500-6,5007,000-38,00065,500-17,50013,00032,5007,0009月合計マイナス32,300引き続き10月分49,500-35,00035,500-10,000今年累計¥254,400です。なんかね~今年の収支って最初生意気な目標を掲げてましたが、勝ててるだけありがたいって展開ですね。9月は北海道に1週間行きましてぼろぼろに負けてきました^_^;等価交換は厳しー。今回はレンタカーでいろんな所に行ったけどどこもガラガラで郊外店はつぶれている店も結構あった。大阪のほうがずーっとましだなと思いました。でも食べ物は…とりわけ海鮮類はさすが北海道。私は貝類が大好きなのですが、つぶ貝ホッキ貝など超新鮮なやつをたくさん食べれてしあわせでした。
2007年10月07日
その後の8月のパチンコ収支です。-3,5001,50024,500-13,5006,000-16,500-1,50011,0001,0007,5008月収支合計¥-14,500年間トータル¥2497007月のように順調にはいきませんでした^_^;仕事のほうが毎日結構忙しく(パチンコに行っているが…)・長期的なメールのトラブル(毎日謝り倒すのに疲れた)・講習会の準備(資料をつくるのにPCの画面を見すぎて目がおかしい)なんか毎日の暑さもあって疲れた8月でした。今日は世界陸上の女子マラソンが目の前をとおるので朝からおきて応援したり、その後たっぷり昼寝をしたりと休日モードで大分元気になりました。早いもので9月に突入。ことしも2/3が終わったのね。来月は情報セキュアドの試験がある。勢いで申し込んだものの勉強がまったくできていない。やめよかな~。はーなさけない。
2007年09月02日
昨日は久しぶりに大きく負けた…¥25000なり前回からの収支は木曜日(仕事帰り)S店3円交換 スパ海となりが店休日だったこともあり、回りは酷い¥11100であたってくれて5箱流して¥23000→\12000のプラス土曜日 ペアでK店へ。ワンワンを打つ。¥3000であたってくれたのだが、チョーしょぼしょぼ展開で結局飲まれて¥3000の負け。日曜日 近所の美容院へカットに行った帰り。ついつい等価のA店へ。アホスパ海を打つ。等価だけあってサスガに背筋も凍るような回りだった。¥3000でありがたいことに単発あたり。時短を消化して上皿分まわして110回…さすがに打つ気もうせて換金する¥5500なり。少ないー。でも¥2500のプラスで、ありがたや~。今後絶対行くまいと思いました。月曜日 仕事帰りにS店へ。沖海を渡り歩いて¥15500の投資で大当たり。確変ワンセット・単発・ワンセット・ワンセット。¥24000の換金で¥8500のプラス。で昨日。久しぶりになんばのN店へ。高島屋に日傘の修理を受け取りにいったのが運のつきだった^_^;それがなければ行ってないもんね。新台入れ替え3:00オープンだったのだが、新台の仮面ライダーに空き台が。¥2000で出玉なし時短。¥7500で大当たり→1回で終了。ムカツク。沖海へ移動。¥2000で大当たり。単発。1回分で180オーバーの回りだったので追加投資。600過ぎまで回した間に魚群4回。全部はずれ。ハラタツー。トータル¥25000使ったところで時間ぎれ。今月¥5000のマイナスです。追記 今日仕事帰りにまた行った。S店単発2回でマイナス¥26000なり。仕事帰りはやっぱダメダメ。
2007年08月08日
最近すこぶる調子がいいのである。1月~6月までいったりきたりでプラマイ0状態だったので今月のプラス収支は本当にひさしぶりでウキウキである。とそんな感じで調子に乗っていたので先週は仕事帰りにN店へ行ってしまった。新台花の慶二がたまたま1台空いており、座ってしまった。1万つかったところで回転数が370と信じられないような回りだったけど、やっと引いた大当たりはなんと1回で終了。継続率80%の台にしてはひどいよね~その後¥3500でなんとかモードでカウンターが0からスタートしたので、隠れ確変にはいったものと勘違いしてその後¥6500まで追加投資。結局あたりをひけず、家に帰って雑誌で確認したら2R通常のあたり(出玉0)を引いたらしい。ムカツク台だわ。結局¥20000の負け。翌日また行ってしまった。また花の慶二が1台だけあいており、座ってしまった。回りは昨日ほどでもないけど、やはり30オーバーは回る。辛いスペックなんですね。むかつくことに¥1000でまた出玉なしのあたりを引く。直後に城門到達演出があったので隠れ確変だったのだと思うのだが、よくわからず¥6500つかったところで台移動。沖海に行く。やっぱりわかりやすいスペックがいいよね。トータル¥20000でやっと大当たり。単発・単発・単発・確変ワンセット・単発で3箱チョイ流して¥14500の換金。¥5500のマイナス。仕事帰りのダメダメパチンコでまけつづけ~で土曜日。自転車でいける距離のA店の12時オープンイベントへ行く。ガラガラのエバの島に座る。ジャスト¥10000で大当たり。2・1・5・4・4・4・2と8時過ぎまでにトータル22回15箱流して¥60000の換金。→ジャスト¥50000のプラス。初めて1分ミッションを見た。しかも5分ミッションの間にいきなり入って5分ミッションを違う図柄であたった!そして昨日。日曜日にゆっくりしたのもあって、仕事帰りにまたまた打ちたくなり、甘デジなら良かろうと自分に甘くなり、3円換金のS店へ。甘デジの義経が1台空いており座る。が、まー回らない。でも面白いので¥7000も使ってしまった。沖海へ移動。最初は結構まわったので打ったのだが、1000回も超えてしまい、この店ははまりがきついので撤退。スパ海へ移動。既に20回当たっており268までまわっている台。これが¥1000であたって単発。時短中に単発。1箱ちょいで確変ワンセット。半箱ほどで6×7の泡のマリンで7で当たる!!!ここからがホントにすごくてこの確変が9連荘。時間はすでに10時すぎ…ありがたや~と思っていると時短中に2であたり3へ昇格。連荘がとまらず閉店10:45に店員さんに終了を告げられハンドルから手を離すと同時にえびで魚群「これまでいいですか?」ときくと苦笑しながら一応OK。結局6回とれて合わせて15連荘!!!17箱流して¥84500の換金→¥59500のプラス夜9時過ぎからの大大大爆発でした。今月収支¥252500今年トータル¥261200
2007年07月31日
先週の金曜日は以前職場の友達と久しぶりに踊りに行った。たまたま同郷の彼女とはたまーに会う間柄だ。先日離婚したばかり!!!でそれについても根掘り葉掘り聞く…離婚の原因は結局のところもともと結婚するほど好きだったわけではなかったということらしい。なんでも中学生からの知り合いでたまたま大人になって二人とも大阪にくることになりお互いいい年齢だし友達付き合いも長いし、結婚してみるか…みたいな感じで一緒になったらしい。ところが結婚してみたら経済観念はまったく違うわ(だんなの方が相当シマリ屋)、細かいことにうるさいわですぐに離婚!ということになったそうだが、旦那の方が(部屋も別々(それぞれにテレビやベッド)経済も別々・ご飯も別々にしてみたらうまくいくかも…と(旦那はなんのかんの言っても彼女のことが好きだったのではないだろうか?)提案してきてその後は数年うまくいっていたらしい。だが、それも限界だったみたいでお互い姿もみない(部屋の外を通るシルエットだけとか)が長く続き離婚にいたったわけである。二人とも浮気するわけでもなく、憎しみあるわけでもなく、でもお互い必要がないということだよね。よーそんな相手と長らく暮らしてたよな…人生もったいなとおもいます。だから彼女の離婚はよかったねぇと思いますわ。彼女も幸せそうだったしね。そんな話を居酒屋で聞いた後でディスコへ。年齢層が私世代の店らしい。金曜日の夜だったけど大雨のせいか結構すいてて快適でした。久しぶりにおどったのでひざが笑ってたけど、楽しかったわ~で前置きが長くなりました、土曜日は疲労でダウン。そんなに飲んでないけど、やはりおどりは足にくる。で日曜日に10時にN店へ入店。久々朝一スタートです。イベントのエバに座る。25ペースでまわり今日はこの台で勝負。最初は¥4000であたっていい感じだったのだが、その後650.で2回。さらに次は1040回で単発。投資もかさんで(¥27000)やばい展開だったけどその後はちょこちょこあたってくれて総大当たり20回10箱流して¥43000の換金!¥16000のプラスです。
2007年07月25日

最近は打つ回数がめっきり減っています。先週は7/7の土曜日。実は私の誕生日は7月7日。パチンコ好きにそりゃなるだろうと思います。子供のころは七夕生まれってなんかロマンチックだけど私はそういうタイプじゃないという違和感がありましたが…この日は彼とペアパチです。必殺を打ちました。結構投資がかかりましたが最後には20箱ほど流せて(ちょっと前なので細かいことは忘れた…)各¥24500ずつのプラス収支。翌日曜日に誕生日のお祝いをしてもらいました。イタリアンのちょっと高級な店でご馳走を食べて満足・満足!!そして7/13の土曜日N店でペアパチ。ところが回らずあたらず…。耐えかねて店移動。既に投資は各¥40000弱…ここでは簡単に当たり(彼がゴジラで6連荘)持ち玉移動ができるのでPurpleExcellent?という変わった台に移動。そんなこんなで結構テキトーな勝負でしたが、最後は8箱ほど流して¥18500ずつの負け…。まあ仕方ないか…次の日。今週は3連休なので日曜日もがんばって打ちました。N店のイベントのスパ海。店に着いたのが13時だったので既に9回当たって450ほど回ってました。¥4000でかに魚群がすなおにあたってくれて7連荘。その後980まではまりましたが後は出っ放し。計32回大当たり。換金¥95000 とたばことおかし。¥91000のプラス!!これで今月15万ちょい。年間累計も16万でMAXです。平日は行かないつもりでしたが、昨日どーしても行きたくなり甘デジ狙いでS店へGO!ところが狙い台は全て満席。仕方なく新台のワンワンへ。¥4500であたって単発。時短中に単発。時短後すぐに単発。時短中に単発。4箱ゲットしましたが、次は3箱なくなりかけでまた単発。1箱ちょい入れて終了。¥3500の換金で¥1000のマイナス。3円交換だし、回りはかなり悪し。一箱130ほど。¥1000の負けですんでラッキーと思わないとね…土曜日までがまんがまん。※先週東京日帰り出張があったんだけど東京駅や品川駅で売っている「貝づくし」という駅弁がオススメです。ラスト一個を買えて幸せを感じました。ハマグリとアサリ小柱がのった炊き込みごはんです。貝好きにはたまりません。
2007年07月18日
先日落ちたMCP 70-281ですが、やっと合格しました登録している派遣会社のキャンペーンでMCP¥15750→\10500というのがあり、この機会に受けないとなかなか次受けれないだろうなと思いぎりぎり6/30に受験して合格!!!先週はパチンコもいかず仕事帰りはドトールで勉強の日々。902点の高得点で合格。うれし…これで足掛け4年かかってMCSAになりました。しばらくは資格取得はとめて会社のシステムの勉強をがんばろうと思います。でも秋のセキュアドも目指したいような気もするしね。パチンコは日曜日イベントの必殺仕事人¥8500であたりその後の追加投資なし。5箱から1箱をウロウロしたが、最後に9連荘をしてくれて¥49000とたばこ2箱ゲット。¥40500のプラスになりました。で今日…仕事帰りは行かないと宣言してましたが…どーしても打ちたくなり甘デジ狙いでいく。A店で沖海の甘デジ \3000で60回も回らすヤメN店でオグリキャップ ¥500で当り、単発だったけど40回転で5連荘で結局4箱近くまで行きました。換金¥17500とタバコ1箱。¥14000のプラスです。なんかちょっといい感じです。
2007年07月03日
前回で今年のMAXまでいったのですが…なかなかね…うまくいきません。その後の収支 ペア打ち 10,000 仕事帰り -45,000 仕事帰り 8,500 仕事帰り -35,000 仕事帰り -25,000 ペア打ち -26,000 昨日 59,000結局今年の収支¥8700昨日は久しぶりに9時間稼働!結論仕事帰りにはもうパチンコいきまっしぇーん。土日に朝からがんばります。以前のブログを読み返していたら仕事帰りは我慢して土曜日に10時からいってたもんね。まじめに土日に頑張ろう!
2007年06月25日
20万までマイナス収支になったりしましたパチンコ収支ですが…やっと少し大きなプラスになりました水曜日一応今週1周年イベントのS店へ。以前歌舞伎剣で勝たせてもらったお店です。義経物語? -4500歌舞伎剣 -5000エバ -5500007 -5000キャーだめだめパチンコだわ~最後に一万沖海で使って帰ろうと座って¥2000で泡のマリンちゃんでえびゲット!ウソみたいこれが3連荘・時短でえびのリーチでハイビスカスがピカピーン!これが8連荘合計11連荘で時短終了で時間は22:30換金¥55000とチョコ2箱¥33000のプラス!!!続いて金曜日。同店仕事が少し遅くなり19時過ぎになった。すごい人で歌舞伎剣は満席。沖海に座る¥10000で移動。回転は203回¥500で移動。ハンドルこわれてた。¥1500で移動。まわらない。¥500 大当り!ラウンド中に確変昇格!これが2連荘・時短引き戻し1.1.1.3でトータル8連荘次に1箱半で2連荘・一箱入れて単発。時短で終了。8箱ちょっとで換金¥41000で¥28500のプラス。これで今年のトータル¥62200です。今年のMAXです。マイナスにならないようにこつこつ頑張ります。余談ですが、今日ジョーバが届いた!ナショナルの乗馬運動の機械です。これでがんがんやせる予定です(はずです…)
2007年06月16日
久しぶりの更新だ!その後の収支は…-7,0001,500-18,00012,0001,500-17,0009,500-4,5005,500なんというまったりした展開でしょう^_^;今年の収支¥700です。ふふふ。勝ってることが重要だ。時給いくらでしょう。試行回数が丁度77回です。1回につき10円以下。ってことは時給は1~2円くらいかな?今月末には出来心でかったプラダのバッグの支払いが…かせがねば…
2007年06月12日
昨日勝たせてもらったT店へ。今日も12時オープンです。彼とペアパチだったのだが、エバに¥3000つかったが回らずヤメ。ウルトラマンへ移動。結構回りそう。¥5000つかったところで大当りゲット!ところが単発^_^;継続80%というのに…二人でこの玉を使って無くなりかけに彼がピグモンのかわいいアニメ背景のプレミアから777その後は追加投資なく彼ががんがん当ててくれました。私はかなりしょぼくてその後も2・0(時短)・5・4・2とぜんぜん連荘しない…彼は総大当り40回オーバー(実質は35回くらい?)彼のおかげで換金は¥92500私は¥37500のプラスになりました。これで今年プラス収支(¥17000ほどですが…)これからはマジで慎重にいこうっと関係ないけど今日行きかけに地下鉄のホームで携帯をつかおうとしたら「こんなところで電話すんな!」とどつかれた!!!!!※ホームは携帯禁止じゃないよね?それに携帯を耳に当てた瞬間の出来事です。 留守番聞いたりするよね~???ちょっと頭のおかしそうな40過ぎくらいの男の人。どう言いかえそうかと構えたところで彼が来てわーーーーと啖呵を切ってくれた。私も言い返した。相手は謝り倒してきた。ちなみにその男のつれの女の人は横で携帯のメールをしてました。意味分からんこれから暑くなるし変な人には注意しようと思いました。
2007年05月27日
昨日の夜は前の職場の友達に会ってたくさん飲んで酔っ払った。私と同じ福岡出身なのだが、先日だんなと別居したときいて!!!久々に会ったのだ。その話で盛り上がったのはもちろんなのだが、パチンコについてもいろいろ聞かれて今年は負けてることを熱く語りました…で今日です。42玉交換から35玉へなったばかりの12時オープンへ行った。打った台はオグリキャップ。¥3000で当って単発すぐに引き戻して2回その後飲まれかけてからがすごかった。ほとんどあたりまくりで9時過ぎで総大当り32回!!!換金¥133500で¥130500のプラス今月の収支プラス¥30500になりました。最高15万近く負けていたのに…今年のトータルはまだ2万ちょっと負けてるけど…でもね今勝ちは大きいです。捨てる神あり拾う神あり?(正しいか?)
2007年05月26日
やっと少し調子を取り戻しつつあるかな?火曜日…仕事帰りにS店へバラエティコーナーでハーロックを打つ。¥1500で確変!!!最近ないわ~こんな展開でも2回で終わり。そのあと突確と単発と確変ワンセット全部のまれて~時間は10時前。投資¥1500だし、甘デジでも打って取り返せないかなとオグリキャップの甘デジへ…¥500で大当り!8連荘で時短2即やめ 換金¥10500。¥8500のプラスです。で本日は…月曜日に少し勝たせてもらった店へ行く。歌舞伎剣は満席だったが、コーヒーを買ったりしてウロウロしていると一席空き台を発見。すかさず座る¥2500で当りゲット。やっぱ甘デジはいいね。これが20連荘。さらに74回転で8連荘7箱てんこ盛り。その後一箱いれて止め。換金¥30000ジャスト¥27500のプラスです。でもまだ今月¥90000も負けてます。先日の¥100000負けが痛いね~(ちなみにその日一回もあたらなかった…)この調子でこつこつ取り戻すわよ~
2007年05月23日
パチンコは…土曜日彼とペアパチ沖海を打った。33玉から36玉へ変更した店で打ったのが回る回ると書いてある割には回らなかった…でも私は結構あてて17回。彼は8回久々に勝てました。¥16000づつのプラスそして今日…月曜日だけど仕事帰りに行ってきました。打った台は歌舞伎剣です。3円換金です。¥4500で当って単発…さらに¥3500投資で10連荘 うれし…次は206回転で単発 次も単発 次も単発(でも15Rだった。ゆうこりん見れた!)そして最後にまた単発…結局3箱弱を流して¥12500の換金とチョコ2箱にキャラメル1箱¥4500の勝ちです。甘デジもいいかもしれません…
2007年05月21日
先週の今頃は必死で勉強してたよな。先週の土曜日 MCP70-218を受験→不合格 ガーンというか 合格ライン700点のところを604点だかた惜しくもなんとも無く…出直します…でパチンコはといいますと…ひどすぎるダダ負けです。-24,500-100,000-21,000-10,000今年のトータル20万以上負けてます。パチンコを始めてハヤ8年以上年間収支-50万-16万+11万+45万+90万+140万+120万+100万そして今年…5月も半ばで-20万勝てるのかな…?景気づけに夏用のプラダの白いレザーのかばんを買ったよ…逃げちゃだめだ!逃げちゃだめだ!(エヴァンゲリオンより)仕事も勉強もパチンコもがんばるのだ~!!!!!!
2007年05月18日
ずーっと更新できなかったよ。パチンコは相変わらず不調です。-25,000-8,50030,00020,50031,000-3,500-2,5009000今年のトータル¥51800のマイナスです。今日は5月初めての勝負で¥9000買った。GWなので勝ててラッキーというところか…本当は勝てないパチンコをしている場合ではないのだ。5/12に試験を受けるのにテキストのまた1/10くらいしか勉強していない…明日から3日は勉強するぞ~!!!
2007年05月03日
今年の最初の日記には…確か今年の目標120万!!!とか大きく書いていましたが。その後の収支は…日曜日(ちなみに等価のみせ) -45,000月曜日 -30,000火曜日 10,500木曜日 -8,000金曜日 8,500土曜日 -11,000今月-¥113500の負けトータル-¥102800 これじゃアキマセン…。
2007年04月15日

大量に文章を書いていたのだが、全部消えたなので要約だけもう一度書こう本日パチンコ大負け¥38500 主にヤマトで負けたけど、最後は桃太郎侍で1627回まわして玉がなくなりヤメ…近所の桜です。きれいでしょ。今週は東京出張があった。新人君たちのシステムの研修のお手伝い。メールの練習のために私も彼らに混じって机につく。溶け込んでいたって… ふふ。後姿だが…久々にインスト気分で楽しかった。
2007年04月07日
久々の日記。パチンコのこと。相変わらずパチンコ行きまくってました^_^;もう記憶にないので収支だけ。 -27,000 21,300 6,300 -14,000 13,600 -11,000 -22,400 79,800最後の収支は本日です。A店でまわらない台をダラダラ打ち、N店へ移動。大ヤマト1/500を打つ。ギャンブラーです。¥2000で当って1.4.2.16.3.2.2で合計30回の大当り。今年初めてこんなに当ったの。うれしーこれでやっとプラス収支。¥21800今年の累計¥10700です。去年の今頃は50万オーバーだったのよ。今年は厳しい。でもやっとプラスになったから4月から気分も新たにガンバロー!仕事のこと。MCSA取得へのラスト試験70-218の申し込みをした。5/12に受験するわー。なので4月は勉強を頑張るのだ。
2007年03月31日
久々の更新。パチンコは…実はこの1週間風邪でダウンしてました。先週の土日は少し熱がでてずーっと家でごろごろ。月曜日は結構しんどかったけど仕事へ火曜日はついに私も花粉症か???とおもうほどくしゃみの連発と鼻水…昼休みに鼻炎の薬を買いに薬局へ。のんだけどいまいち効かないし、なにより頭がボーとして夕方からは悪寒が…定時であがってダッシュで家へかえるけど寒く寒くて…お風呂に入っても変わらず。だんだん熱くなってきて熱を測ると39・25度その後はあんまり意識なし。朝起きても38・5度と高いまま。さすがに仕事は休んで病院へ。インフルエンザの検査をしてもらい陰性で少ほっ。注射を打ってもらって薬もたっぷりもらって家でひたすら寝る。ここから好転するのだが、マジでしんどかったわ~これには後日談があり、もらった薬に中の抗生物質が倍の量処方されていたのだ^_^;なんかきくけど体調がおかしいと感じてネットでしらべたら250mgの処方が500mgになっていた。かなりおじいちゃん先生だったからねぇ。3回ほどその量でのんだけど…こわいよね。翌日からは仕事にいったけど貧血状態で頭がまわらなかった。しかも仕事で4月からのあたらしい勤務カードを作っているのだ。(完成したけど。)私のExcelの技術を最大限までつぎ込んで作成しました。関数なんかネストしすぎてもうできないくらいif関数をつかいました。ここまで書いて疲れた。まだ病み上がりなもんで。パチンコはその後金曜日 ¥7100土曜日 ¥-25000日曜日 ¥-4800と相変わらずのまけまけ展開。でもひとつ最近の敗因をみつけたわ。というか去年と違うところ。換金率¥2.38に行かず3円とかの高換金率にいっていた。それは止めにする。換金率¥2.38で地道にまわすのだ~
2007年03月19日
3月の収支ですが…2月に結構勝たせてもらったF店へ行くが…月曜日新エバをうったけど¥7,100の負け。火曜日いろいろ打ってだめだめパチンコ¥15,200の負け。ダダーン。6連敗さすがに店を変えました。グランドオープンしてまだ1週間ほどの店へ行く。木曜日 新エバを打つ。やっとで連敗脱出 ¥20,200のプラス。今月これで¥2100のマイナス。なんかね~仕事帰りに疲れた体で打ちに行く意味ありませんよ。これじゃ敗因は???回転数???時間が足りない???う~ん。話は変わりますが先日家の近くの整骨院で血液さらさらチェックというのを¥1000で受けてみた。よくTVとかの健康番組でタレントさんとかが受けてるやつ。前からやってみたかったんだ。というのも私の食生活はとても偏っていて・野菜は食べない(野菜ジュースは飲む)・基本的に肉食・毎日お酒はかかさない(といってもビールを少しと最近はワインを1杯ほどだけど)どろどろの血だろうな~と思って目で見てみたいなと思ったいたのだ。上がその画像時もらった私の血液(赤血球?)を拡大したものですが、結構サラサラだったのよ♪時々円形がくずれているのがあるんだけど、これは胃腸が弱っている現象とのこと。まさにそのとおりだったので…びっくりオススメです。これ。
2007年03月09日

しばらく書いてなかったよ。その後は3連敗です。試験勉強をしなくてはいけないから今週は仕事帰りにパチンコ行かないと心に決めていたのだが、そんな決心はもろくも崩れ去り…月曜 -¥17,000火曜日-¥12,100水曜日-¥12,700結局先日から4連敗で2月終わり。2月のトータル¥51,000MAX10万こえていたのにね~1月が¥62100の負けだから結局¥11100の負け。でも昨日受験したMCP70-271の試験は合格!!!130分の試験時間だったのだが、久々に頭を使ってすごーーーく疲れた。これでMCP4個目だよ!!!あと一枚去年購入していたバウチャーチケットが5/17までの使用期限なのでそれまでにもうひとつ受けるつもり。そうしたらMCSAになれるのだ。明日早速テキストを購入するつもり。今年はどーもパチンコの調子が悪い分資格取得をがんばるぞ~!!!話は変わるけど以前書いたことがあったけどホームレスの人を支援する為の雑誌BIG ISSUE(ビッグイシュー)一ヶ月に2回刊行してて販売員の人はホームレスの人だ。私は職場の近く購入していますが、この雑誌本当に中身がおもしろのだ。¥200なのだが、このうち¥110が販売員の人の収入になるわけ。イギリスが発祥の雑誌です。東京では結構有名らしい。大阪でも結構ひろがってきているとのこと。ホームレスのおじさんに少しの支援ができるし、雑誌もおもしろいのでぜひオススメです。ちなみに上の写真は3/1号です。ニコラス・ケイジのインタビューなどがのっています。
2007年03月04日
今週は…というか最近はヘルプデスクの仕事が忙しい。しかもストレスも結構あるわ~。仕事にストレスはつきものだと思うし、イラつく人間に遭遇するのもこれまた良くあることだよね。ただ考え方を変えて…そのむかつく仕事をしないMさんに対して仕事しろ!もっとペース上げろ!とは考えず自分の中で最高に効率よくミスを減らしてやればその人は自分にとって必要なくなると思って毎日7時間15分ベストを尽くして力を出し切るのだ~と思って最近ががんばっているのだ。と話は変わってパチンコですが、火曜日と水曜日は残業で打てず。木曜日は早出でくたくただったのだが、すごーく打ちたくて定時でダッシュでF店へウルトラマンを¥15000打つがあたらずハーロックへ移動¥4000で大当り2連荘細かくはわすれたけどいったん6箱までなってその後2箱打って時間が10時前だったので残り4箱を流してももらい最後の上皿分を打っていたらエメラルダスの「覚悟しなさい!」こりゃあたるかもと財布をとりだしてみていたら大当り。あわてて¥1000を入れる単発だったので時短を消化して上皿分を下皿へ流していたら保留2個目でアルカディアモードへ突入!時間が無い中結局5連荘してくれて時短を消化できたのがちょうど10:45のタイムリミット。換金¥48200で¥28200のプラス!!!!体はくたくただったけどストレスも吹き飛んだわ~明日もがんばるぞ~と金曜日張り切って仕事へでかけたのだが、またもやいらいらする出来事が重なって頑固なマイペースの向上心がないMさんのせいではないことに対して最初から決め付けるような態度を一日中とってしまい結局最後にMさんのせいではなかったとわかり…なんか後味の悪い日だった。軽く反省。来週からは以前のようにやさしく接するようにしようと思う。マジで。本日土曜日。彼とペアでうちにいく。新エバを打つも彼→2回私→6回全部のまれた。時間もあったので店を転々と…結局最後は3円の店で大海を打つ彼→0回私→7回4箱流して¥19500の換金二人でトータル¥46500つかっていたので¥13500づつの負け彼当てなさ過ぎ。海も沖縄バージョンが近々入るからどこもえぐいのか???明日は3/3の試験へ向けて勉強しなければ…
2007年02月24日
最近タイトルこればっかのような気がするわ…その後は先週の火曜日ウルトラマンスパ海ハーロックとわたり歩いて結局¥1,100のマイナス先週木曜日ウルトラマン千円で777!17連荘(ビッグ10レギュラー7)¥50,200のプラス!!!そして今日はじめてエバに空き台があり¥3000打つけど鬼回らない移動ハーロックで¥9000で3連荘のまれかけで単発。結局のまれるウルトラマン¥2000スパ海¥8000エバ¥3000結局¥25000の負け帰りに最初に¥3000打ったエバが19回あたっていた。ショックこれで今月¥78100のプラス年間トータル¥16000のプラス。帰りの地下鉄でMCPの勉強をする。仕事してパチンコして勉強して…忙しい。負けるとつらいわ~でも今日のパチンコは駄目よね。でもまわらなかったから仕方ないよね。はー
2007年02月19日
その後の収支ですが、あと¥6100でプラマイゼロのところまで行っていたのだが…先週は月曜日 珍しく仕事で23:00前まで残業…迷惑メールの対策の機械を導入してのテストをしたのだ。やっぱり残業って苦手"^_^"ホームシックになってしまう。パチンコだったらぜんぜん平気で11時まで頑張れるのに…火曜日今月2連勝のF店へ新エバが入って大賑わいだった。ハーロック・スーパー海で結局¥26,200の負け。水曜日同F店へウルトラマンで今年最大の勝ち(^^♪最後に13連荘して(big11回レギュラー2回)で¥71,500のプラス!!!!これで今年の収支が初めてプラスに¥39000のプラス!!!木曜日仕事帰りに買い物(昨日久々に大勝ちしたので財布の紐がゆるくなる)百貨店の最終バーゲンで70%のワンピを買う。ガブリエラバジーレ??結構高級ブランドな感じ。カシュクールタイプのジャージ素材の黒でいい感じなのだ。土曜日彼とペアパチへ…のつもりがまわらなのでばらばらに打つ。1機種1席のイベント席のハーロックを打ったけどやっとあたったのは¥44000使ったところ1208回だったと思う^_^;その後ははまらなかったけどとりもどせず¥20,300の負け。アーア日曜日ゆっくりするつもりが早く目が覚めたのでまたもやパチへ行く。3円換金になった店のイベントへまったく回らずいろいろ打って¥10000使ったところで移動今月かってるF店へ。人気店らしく座る席もない。仕方なくA店へ移動。ゆっくり打てるし昨日見にだけいったら結構でてたし。ウルトラマンを打つ。結局¥17000つかったところで当ったけどのまれて終わり。トータル¥27,000の負け。せっかくプラス収支にいったのにトータル¥8100のマイナス。でも今月だけでみると¥54000のプラス。まあまだまだ頑張れるよね。MCPの試験を申し込んだ。3/3に受験予定。勉強もしなくては…今年は忙しいよ
2007年02月12日
全247件 (247件中 1-50件目)


